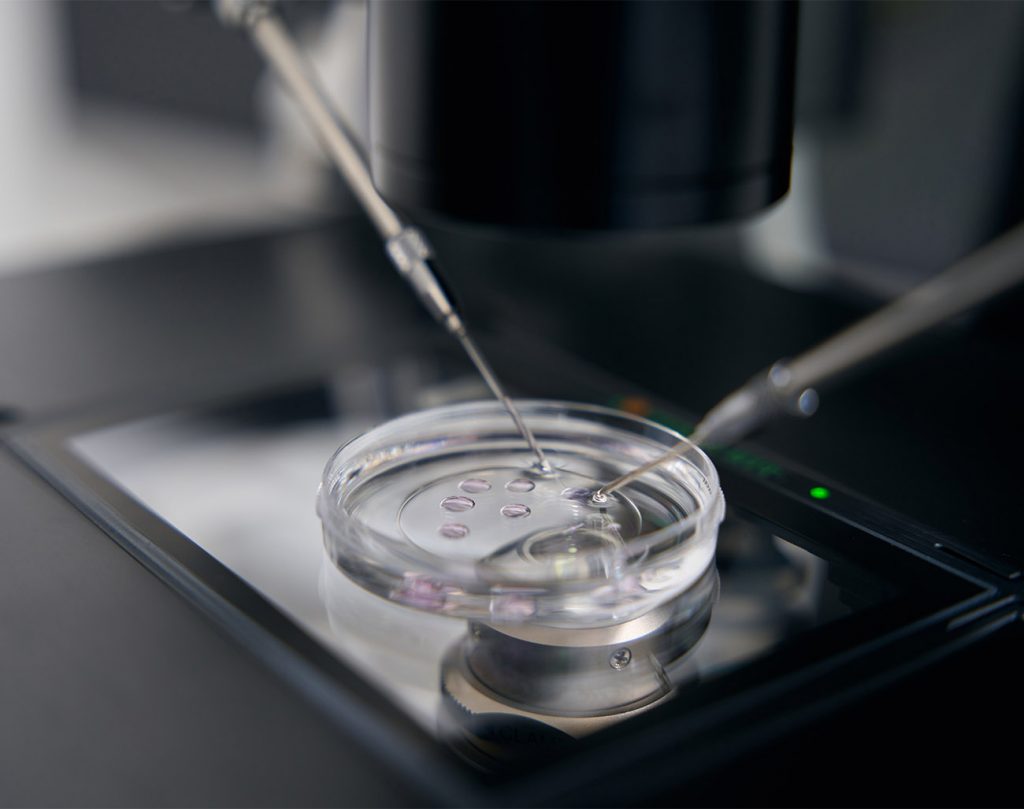

cuidamos tu salud.

y Unidad Móvil.
Nuestros Servicios y Proyectos
Nos esforzamos en darte en cada servicio la atención, cuidado y calidad que mereces
Somos D'María
Un equipo de profesionales dedicados a revisar y cuidar de tu salud.
Misión
Nuestra misión es proporcionar resultados precisos y confiables para ayudar al diagnóstico médico y así mejorar la calidad de nuestros pacientes.
Visión
Queremos ser reconocidos por nuestra integridad y compromiso con la salud de la sociedad en San Luis Potosí y México.
Valores
Nos comprometemos a servir con integridad, profesionalismo y cuidado por el paciente.
Nuestro Trabajo
Nuestros Servicios
Comunicación
Transparente:
En Laboratorios D'María, comprendemos la importancia de una comunicación clara y transparente con nuestros pacientes. Nos esforzamos por tener la tecnología de vanguardia, calidad y atención para la salud de los pacientes. Estamos disponibles para aclarar cualquier duda desde el proceso de tomas de muestras hasta la entrega de resultados, brindando a nuestros pacientes la tranquilidad y atención que merecen.
Procesos de Calidad:
En Laboratorios D' María, mantenemos estrictos estándares de calidad en todos nuestros procedimientos. Desde la toma de muestras hasta el análisis y la entrega de resultados, cada caso se realiza con precisión y cuidado.
Nuestro equipo de profesionales capacitados y equipos de vanguardia nos ayudan a contar con resultados confiables y oportunos.
Sobre nosotros
En Laboratorios D'María, no solo somos un equipo de profesionales, somos un grupo dedicado a su bienestar. Desde nuestro inicio, hemos forjado una sólida reputación en nuestro servicio, y nuestra pasión por lo que hacemos es palpable en cada paso que damos.















